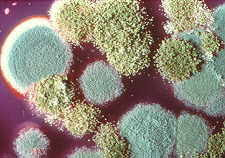

Post ten ma głównie na celu sprawne poruszanie się po dziale „TEGO UNIKAJ”. Oprócz tradycyjnych toksyn znajdziesz tu substancje ogólnie niewskazane dla osób chorujących na choroby autoimmunologiczne.
W naszym otoczeniu występuje niemal 100 tys. różnych związków chemicznych. Wiele z nich, o ile nie wszystkie, ma właściwości toksyczne. Wiele z nich przedostaje się do organizmu i osiada w nim na dobre. To ogromne obciążenie dla każdego człowieka, a tym większe dla osób cierpiących na chorobę autoagresywną lub nią zagrożonych (Test). Osoby chore przewlekle kontakt z tyloma chemikaliami może skazać na życie w bólu i chorobie do końca życia.
Skorowidz Toksyn
Toksyny ciężko jest pogrupować tematycznie, ponieważ dana toksyna potrafi występować w wielu obszarach naszego życia. Weźmy przykładowo metale ciężkie: aluminium znajdziesz w garnkach i kosmetykach, rtęć – w rybach i plombach dentystycznych, a ołów w instalacjach wodociągowych.
Z uwagi na złożoność i wagę tematu, toksyny postanowiłam po prostu wymienić według własnego uznania i pobieżnie opisać. Bardziej szczegółowych informacji szukaj w niezależnych postach.
Neurotoksyny, czyli toksyny wpływające bezpośrednio na funkcjonowanie mózgu, które uważam za wyjątkowo groźne – oznaczam gwiazdką. W depresji, czy letargu umysłowym ciężko jest cokolwiek ze sobą zrobić.
Podział toksyn:
- Pestycydy *
-
Ekscytotksyny *
- Glutaminian Sodu (MSG)
- Aspartam
- Hydrolizowane Białko Roślinne
- Metale ciężkie *
- Teflon *
-
Elektrotoksyny *
- Telewizory
- Komputery i klawiatury
- Kuchenki mikrofalowe i jonizowana żywność
- Telefony komórkowe
- Sieci wi-fi
- Suszarki do włosów
- Anteny
- Satelity
-
Pleśnie – Mikotoksyny
- Aflatoksyna
- Zearalenon
- Sterigmatocystyna
- Sporysz
- Cytochalazyna B
- Kwas Kojica
- Toksyna T 2
- Pleśnie sorgo
- Patulin
-
Dioksyny – Rozpuszczalniki – Solwenty
- Benzen
- Alkohol Propylowy
- Trichloroetan (TCE)
- Ksylen
- Toluen
- Metanol (spirytus drzewny)
- Chlorek Metylenu
- Ksenoestrogeny i Bisfenol A (BPA)
-
Halogenki – Fluorki
- Chlor
- Brom
- Fluor
- Leki *
- Żywność
- Cukier rafinowany
- Gluten
- Żywność GMO
- Tłuszcze trans
- Mięso
- Nabiał
- Substancje antyodżywcze (kwas fitynowy, goitrogeny)
- Konserwanty
- Benzoesan sodu (E211)
- Aspartam
- Tartrazyna (E102)
- Barwniki
- Benzoesan
- Benzoesan potasu (E212)
- Ester kwasu p-hydroksybenzoesowego
- Bifenyl
-
Używki
- Kawa
- Czarna herbata
- Yerba Mate
- Napoje gazowane i energetyczne
- Alkohol
- Papierosy
- Stres
- Przepracowanie
- Zbyt mała ilość snu
- Strach (Louise Hay)
- a również nadmierne pobudzenie seksualne
Pestycydy *
Pestycydy uważane są za najniebezpieczniejsze toksyny dla zdrowia mózgu. Dlaczego? Z założenia stworzono je w celu zabijania organizmów żywych.
Istnieje jasny, naukowo udowodniony, związek pomiędzy ekspozycją na pestycydy, a zachorowaniem na choroby autoimmunologiczne mózgu, takie jak Choroba Parkinsona, Stwardnienie zanikowe boczne i inne choroby neurologiczne.
Jednakże fakt niezachorowania na Parkinsona nie oznacza, że pestycydy nie zebrały w mózgu swojego żniwa. Pamiętaj, na każdego z nas toksyny oddziałują tak samo (więcej – cz. 1).
Ten sam podstępny proces, który prowadzi do wszystkich chorób neurologicznych, zaczyna się od ataku wolnych rodników i stanu zapalnego. Brzmi znajomo? To główne dwie „zasługi” działania toksyn na Twój organizm (więcej – cz. 1).
To co ma dzisiaj miejsce na polach uprawnych kukurydzy (ale nie tylko), mi osobiście nie mieści się w głowie. Firma Mosanto, produkująca Roundup (popularny pestycyd), zrewolucjonizowała totalnie wszelkie pola uprawne. Kukurydza nie jest zatem produktem, który chętnie konsumuję, tym bardziej moje dzieci.
Czy wiedziałeś, że na pole kukurydzy “zainteresowani” wchodzą w masce? Niestety te smutne wieści dotyczą również ostatnio naszego rodzimego owsa, co jednocześnie stawia pod znakiem zapytania “zdrową owsiankę”.
Ekscytotoksyny * – Glutaminian Sodu (MSG), Aspartam i Hydrolizowane Białka Roślinne
Ekscytotoksyny to dodatki stosowane do żywności, aby lepiej nam „smakowała”. Bardzo silnie pobudzają układ nerwowy i finalnie prowadzą do uszkodzenia zdrowych komórek nerwowych.
Glutaminian sodu i aspartam zaraz po zjedzeniu potrafią wywoływać bóle i zawroty głowy, oszołomienie i palpitacje serca. Jest to tak powszechne zjawisko, że nazwano je „syndromem chińskiej restauracji”.
Aspartam dodatkowo posądzany jest o właściwości kancerogenne. W organizmie rozkłada się na kwas mrówkowy i formaldehyd. Obie substancje są silnie trujące.
Ekscytotoksyny coraz częściej wiązane są z chorobami neurodegeneracyjnymi takimi jak:
- Alzheimer
- Parkinson
- Stwardnienie zanikowe boczne – SLA
- Pląsawica Huntingtona
- otępienie
- udary
Nawet zwykłe ubytki w pamięci, łagodne pogorszenie funkcji intelektualnych, czy utrata koordynacji ruchowej wiązane są z nadmiernym spożywaniem ekscytotoksyn.
Metale ciężkie *
Istotą rzeczy metali ciężkich jest ich toksyczne działanie (mutagenne i teratogenne) oraz wpływ na enzymy i funkcje błon biologicznych.
Z metalami stykasz się wszędzie
Biochemicy dobrze wiedzą, że minerały w surowej, nieprzetworzonej chemicznie lormie hamują działanie enzymów wykorzystujących te minerały. Miedź zawarta w spożywanym mięsie i warzywach jest niezbędna dla organizmu, natomiast nieorganiczna miedź zawarta w naczyniach kuchennych bądź instalacji hydraulicznej jest karcynogenna, czyli rakotwórcza.
Niestety, metale w formie nieorganicznej przenikają do naszego środowiska – nosimy metalową biżuterię, spożywamy chleb wypiekany w metalowych aluminiowych formach, pijemy wodę z metalowych rurociągów.
Złoto i srebro wydają się być mniej szkodliwe, jednak lepiej unikać kontaktu czystego kruszcu ze skórą, czy tkanką.
Puszki, konserwy żywnościowe i garnki zawierają często aluminium. Dzisiejsze puszki dodatkowo wyściełane są groźnym Bisfenolem A.
Kosmetyki i materiały dentystyczne zawierają nikiel i chrom.
Plomby dentystyczne
Innym, niemniejszym, zagrożeniem są plomby dentystyczne. Wypełnienia w postaci amalgamatów rtęciowych, pomimo dopuszczenia przez Amerykańskie Stowarzyszenie Stomatologiczne, nie są bezpieczne.
Dr Hulda Clark w swoich opracowaniach stwierdza, że niekiedy rtęć może być jeszcze dodatkowo zanieczyszczona talem – meta¬lem bardziej toksycznym od rtęci!
Do silnie toksycznych metali należą w szczególności:
- Arsen
- Rtęć
- Ołów
- Kadm
- Tal
- Aluminium (mniej toksyczny, ale wiązany jest z wieloma chorobami neurologicznymi, szczególnie Alzheimerem)
Czytaj więcej:
-
Toksyczne metale ciężkie – tykająca cicha bomba w Twoim organizmie
-
Rtęć – jedna z najbardziej toksycznych substancji na naszej planecie
-
Aluminium – praprzyczyna chorób neurologicznych mózgu
-
Skorowidz występowania metali ciężkich
Teflon *
Mówi się, że teflon to „azbest XXI wieku”. Wykazuje tendencję do odkładania się w tkankach mózgowych i zaburza pracę układu odpornościowego. Zarysowane patelnie są ponadto rakotwórcze.
Naukowcy tacy jak Rick Smith i Bruce Lourie, którzy prowadzili badania nad substancjami toksycznymi, ostrzegają przed zgubnymi skutkami teflonu. Przekonują, że:
Teflon (kwas perfluorooktanowy):
- jest toksyczny
- powoduje wady wrodzone
- powoduje zaburzenia rozwojowe i hormonalne
- podwyższa poziom cholesterolu
- uznany jest za potencjalny czynnik rakotwórczy
Elektrotoksyny *
Elektrotoksyny, do których zalicza się telewizory, komputery, kuchenki mikrofalowe, telefony komórkowe, anteny, sieci wi-fi i suszarki do włosów stały się nieodłącznymi towarzyszami człowieka XXI wieku. Kłopot w tym, że wszystkie te nowoczesne atrakcje są wyjątkowo szkodliwe dla delikatnych komórek mózgu. Powiększają one ryzyko zachorowania na guza mózgu i inne formy nowotworów.
W badaniach zauważono ogromny wzrost zachorowań na *chorobę Alzheimera* wśród osób wykonujących zawody związane ze zwiększonym kontaktem z polami elektromagnetycznymi. Chodzi tu głównie o elektryków, operatorów maszyn, szwaczki i spawaczy.
Bardzo niepokojącym aspektem jest dzisiaj nadużywanie telefonów komórkowych, w szczególności przez dzieci. Mózg dziecięcy i układ nerwowy nie są jeszcze w pełni wykształcone i używanie telefonów komórkowych może mieć destrukcyjny wpływ na rozwój neurologiczny młodego pokolenia.
Czytaj więcej:
-
Jonizator, czyli częściowa walka z elektrotoksynami
-
Filtr do maskowania niebieskiego światła z komputera jako częściowa walka z elektrotoksynami
Mikotoksyny – Pleśnie
Mikotoksyny to toksyny wytarzane przez pleśnie i grzyby Candida. Z powodu ich niezwykłej toksyczności już niewielka ilość mikotoksyn potrafi zatrzymać pracę części wątroby na kilka dni!
Mikotoksyny to jedne z najbardziej toksycznych substancji.
Wystarczy jeden spleśniały owoc lub warzywo na tysiące niespleśniałych, aby skazić całą dostawę soku, dżemu lub innego produktu, a to już wystarczy, aby zaszkodzić wątrobie.
Mimo że pleśń, jako żywą materię, można wyeliminować, nie można tego zrobić z produktami jej metabolizmu, które muszą zostać zneutralizowane przez wątrobę.
Produkty odpadowe Candidy
Candida w swojej zaawansowanej fazie mocno zwiększa kwasowość organizmu. Powodem są właśnie duże ilości kwaśnych trucizn – mikotoksyn i aflatoksyn, wytwarzane przez te grzyby jako produkty przemiany materii. Uwalniane są one do krwi i rozsiewane po całym organizmie.
Jeżeli problem ogólnoustrojowego zakażenia Candida nie zostanie rozwiązany i te trucizny nie będą odpowiednio neutralizowane i dostatecznie usunięte, to organizm osiągnie w rezultacie skrajny punkt kwasowości – stan kataboliczny.
Czytaj więcej – Przewlekła Candida systemowa – czym jest i jak objawiła się u mnie?
Dioksyny – Rozpuszczalniki – Solwenty
Rozpuszczalniki służą, jak sama nazwa wskazuje, do rozpuszczania substancji. Zwykła woda jest niezbędnym, życiodajnym rozpuszczalnikiem. Większość innych rozpuszcza tłuszcze biorące udział w formowaniu błon komórkowych, szczególnie błon komórek nerwowych. Zagrażają więc one życiowym procesom w organizmie.
Z rozpuszczalników wyróżniamy:
- Benzen – najgroźniejszy z rozpuszczalników. Dostaje się do grasicy i rujnuje nasz system immunologiczny, ułatwiając rozwój AIDS
- Alkohol Propylowy – gromadzi się w wątrobie. Wywołuje stany nowotworowe w innych, nawet odległych narządach
- Trichloroetan (TCE)
- Ksylen
- Toluen
- Metanol (spirytus drzewny)
- Chlorek Metylenu
Rozpuszczalniki, a endometrioza i nowotwory
Dlaczego rozpuszczalniki (solwenty) odgrywają szczególną rolę dla kobiet z endometriozą? Dr Hulda Clark twierdzi, że kumulują się one w różnych narządach przyciągając tam pasożyty odpowiedzialne za endometriozę i nowotwory.
Twierdzi, że nowotwory istnieją od kiedy do żywności zaczęto dodawać rozpuszczalniki.
Czytaj więcej:
Ksenoestrogeny – Plastik – Bisfenol A (BPA)
Ksenoestrogeny to w skrócie plastik. I tu uwaga, w szczególności dziewczyny z endo! Ksenoestrogeny to syntetyczne związki chemiczne emitujące estrogen i zakłócające pracę układu wewnątrzwydzielniczego.
Groźny Bisfenol A
Jednym z groźniejszych jest Bisfenol A (BPA). Jego obecność:
- wywiera szkodliwy wpływ na gospodarkę hormonalną
- powoduje wady rozwojowe płodu lub niemowląt
- powoduje przedwczesne dojrzewanie dzieci,
- obniża płodność
- zwiększa ryzyko zachorowań na nowotwory i wiele innych schorzeń
BPA jest szczególnie niebezpieczny dla dzieci, u których stwierdzono najwyższe poziomy tej substancji.
Plastiku uniknąć nie sposób, wiem. Sama używam go na co dzień i nie potrafię bez niego żyć. Ograniczyłam jednak styczność z nim do minimum i staram się przede wszystkim wybierać plastik bardziej bezpieczny.
Halogenki – Fluorki
Chlor, brom i fluor, należące do tzw. fluorków, to trzy związki konkurujące w organizmie z jodem i często go zastępujące. Odpowiadają za wzrost liczby zachorowań na choroby tarczycy i inne zaburzenia hormonalne.
-
Chlor
Wydaje Ci się, że z chlorem masz głównie do czynienia na basenie? Na basen chodzisz raz na jakiś czas, a mimo wszystko chloru używasz codziennie.
Chlor to zmora dzisiejszych środków higieny osobistej. Wszystkie „watowane” produkty bielone są chlorem i talem, żeby były śnieżnobiałe, żebyś przypadkiem nie przestraszył się „brudnej szarości”. A w całym tym procesie produkcji uwalniają się jeszcze dioksyny! I tak używasz chlorowanych:
- płatków kosmetycznych
- wacików do uszu
- papierowych ręczników
- chusteczek higienicznych
- podpasek i tamponów
- pieluszek dla dzieci
- bandaży
- i wielu wielu innych sterylizowanych chlorkiem rtęci środków
Z chlorem skutecznie walczy Tiosiarczan Sodu (STS).
-
Brom
W tarczycy tradycyjnie już badania wykrywają obecność chloru i bromu – dzisiejsze składniki chlebów sklepowych, które zastąpiły jod wiele lat temu. Wszystkie trzy mają walory wypiekowe, jednakże jod to lekarstwo, a chlor i brom to trucizny jakich mało.
-
Fluor
Fluorowana woda była początkowo produktem naturalnym, gdyż wykorzystywano w niej fluorek wapnia. Obecnie stosuje się fluorek sodu – toksyczny odpad po produkcji aluminium.
Co prawda warszawska woda nie jest już skażona pod tym względem, co nie czyni jej jeszcze zdatnej do picia prosto z kranu (czytaj więcej). Jednak nie tylko w Warszawie żyjemy..
Pamiętaj, że mało jaki filtr usuwa fluor z wody. Skutecznie zrobi to na pewno boraks.
Leki *
Jeśli stajesz się zapominalski, masz niski poziom energii psychicznej i zmienne nastroje, jesteś drażliwy, albo czujesz, że nie masz już tak „ostrego” umysłu jak kiedyś – objawy te mogą być wywołane lub nasilone przez nadużywanie leków na receptę lub bez:
- Pigułki hormonalne
- Leki zobojętniające kwas żołądkowy
- Leki NLPZ
- Antybiotyki
- Antydepresanty
- Szczepienia
- Syntetyczne witaminy
Nie ważne, czy stosujesz środki hormonalne, czy za każdym razem, gdy zaboli Cię brzuch sięgasz po leki zobojętniające kwas żołądkowy, czy zażywasz leki antydepresyjne, przeciwcholesterolowe, czy przeciwbólowe.
Wszystkie te leki:
- zakłócają optymalną pracę Twojego mózgu – niszczą komórki mózgowe, czyli postarzają Twój mózg – zwiększają prawdopodobieństwo demencji starczej w późniejszym wieku
- hamują produkcję endorfin w mózgu – hormonów szczęścia i antyoksydantów
- zawierają w składzie substancje sprzyjające powstawaniu stanu zapalnego
- niszczą witaminy z grupy B – dlatego stanowią toksyny dla układu nerwowego
- zubożają składniki odżywcze w organizmie – prowadzą do anemii (np. rozrzedzająca krew aspiryna)
- powodują krwawienia jelitowe (słynna aspiryna)
- hamowanie bólu lekami NLPZ powoduje wzrost toksyczności ciała
- zaburzają rozpoznanie stanu odwodnienia komórkowego
- NLPZ obniżają poziom tolerancji na ból
- zwiększają ryzyko nadciśnienia, zawału serca i udaru mózgu (np. aspiryna)
Czytaj więcej – Endometrioza, a syntetyczne hormony
Żywność
Cukier rafinowany
Tak tak, na mojej liście toksyn wymieniam też cukier. I bynajmniej nie chodzi o kalorie.
Już 1957 roku dr William Coda Martin sklasyfikował cukier rafinowany jako truciznę. Dlaczego cukier jest toksyczny? Przede wszystkim dlatego, że spożywamy go zbyt dużo.
Ta najsłodsza trucizna jest 8 razy bardziej uzależniająca niż kokaina!
Wiele różnych schorzeń, zarówno fizycznych, jak i psychicznych ma bezpośredni związek ze spożywaniem czystego rafinowanego cukru czyli sacharozy. Cukier podnosi poziom trójglicerydów i insuliny we krwi.
Dr Bruce Fife, czy David Perlmutter w swoich publikacjach donoszą, że cukier to pierwsza substancja do odstawienia jeśli rozchodzi się o choroby degeneracyjne mózgu (Parkinson, Alzheimer, demencje, stawardienie rosiane i zanikowe boczne). Zmęczenie, stres, depresje, senność, bóle zawroty głowy, czy problemy z pamięcią to tylko początkowy czubek góry lodowej.
Pamiętaj też, że Candida i nowotwory żywią się i rosną na cukrze!
Osobiście cierpiałam kiedyś na straszne migreny. Próbowałam naprawdę wielu rzeczy, ale moje bóle głowy diametralnie zmalały dopiero wtedy, kiedy odstawiłam cukier (czytaj więcej)
Gluten
Tak, wiem – gluten teoretycznie nie jest toksyną. Postanowiłam jednak dodać go do mojej listy, gdyż osobiście uważam go za groźną substancję, ponieważ:
- Zawiera lektyny, saponiny, allokasn i brom – wszystkie substancje są toksynami.
- Dzisiejszy gluten to GMO w czystej postaci! Budowa genetyczna dzisiejszego ziarna jest całkowicie inna niż starego, „poczciwego” glutenu.
Dzisiejszy gluten to nie jest ten sam gluten, który był obecny w pszenicy 40 lat temu. To jest zupełnie inna substancja! Budowa genetyczna dzisiejszego ziarna jest całkowicie inna niż starego „poczciwego” glutenu.
Żywność GMO
Dr Amy Myers w swojej książce „The Autoimmune Solution” sugeruje, ze żywność GMO jest prawdopodobnie jednym z największych zagrożeń naszych czasów. Stanowi poważne zagrożenie dla zdrowia, a w szczególności dla osób chorujących na schorzenia autoagresywne i kwalifikujących się na spektrum autoimmunologicznym (Test).
Już trzy miesiące badań na szczurach karmionych GMO wystarczyły, aby w ich wątrobie i nerkach pojawiły się zmiany dowodzące toksyczności roślin modyfikowanych genetycznie, które pryskane były herbicydami. Badania wykazują, że uprawy GMO rzeczywiście szkodzą naszemu zdrowiu.
Mięso
Nabiał
Jonizowanie żywności
Konserwanty
Nie ma co rozpisywać się zbytnio na temat wszystkich konserwantów, gdyż w żywności mamy ich naprawdę sporo.
Naucz się chociaż je rozpoznawać na etykietach:
- Benzoesan sodu (E211)
- Aspartam
- Tartrazyna (E102)
- Barwniki
- Benzoesan
- Benzoesan potasu (E212)
- Ester kwasu p-hydroksybenzoesowego
- Bifenyl
Wszystkie są mocno drażniącymi środkami powodującymi alergie i wiele innych dolegliwości zdrowotnych.
Poważne obawy budzą jednak dwa pierwsze, tj. benzoesan sodu i aspartam (należący również do Ekscytotoksyn).
Benzoesan sodu
Benzoesan sodu to w skrócie napoje gazowane, choć to spore uogólnienie tematu. Stosowany w celu zapobiegania pleśniom.
W przeszłości E211 został zidentyfikowany jako pośrednia przyczyna raka. Kiedy miesza się on z dodaną do napojów witaminą C wytwarza beznen – silny rozpuszczalnik i substancję rakotwórczą.
Benzoesan uszkadza ważny obszar DNA w „generatorze energetycznym” komórek, co może powodować ADHD u dzieci, chorobę Parkinsona i inne choroby degradujące układ neurologiczny, zwłaszcza w starszym wieku.
Ponadprzeciętne dawki E211 w badaniach na szczurach wykazały:
- zaburzenia ze strony centralnego układu nerwowego
- zmiany histopatologiczne w mózgu
- utratę wagi
- zmiany wagi organów
- zmiany parametrów surowicy
- a nawet zmiany histopatologiczne wątroby
Używki
Wszystkie używki są „słodkie” w spożyciu, ale „gorzkie” w skutkach. Używki to takie substancje, które powodują nadmierne (nienaturalne) pobudzenie. Są toksynami dla układu nerwowego, ponieważ wywołują silną reakcję obronną w organizmie.
Używki w moim rozumieniu to:
- Kawa
- Czarna herbata
- Yerba Mate
- Napoje gazowane i energetyczne
- Alkohol
- Papierosy
- Stres
- Przepracowanie
- Zbyt mała ilość snu
- Strach (Louise Hay)
- a również nadmierne pobudzenie seksualne
Wszystkie używki silnie oddziałują na Twój system nerwowy, a organizm w efekcie produkuje hormony stresu, m.in. adrenalinę.
Miej na uwadze, że ten pożądany, pozorny wzrost energii jest wyłącznie wynikiem reakcji immunologicznej w Twoim organizmie.
Kosmetyki
Może Ci się wydawać, że kosmetyki to jedynie igła w stogu siana wśród toksyn. Pomijając jednak temat kosmetyków narażasz swój organizm na kolejne źródło bombardownia chemikaliami. Nic tak nie chłonie przeróżnych substancji jak skóra. Mówi się, że skóra niekiedy nawet lepiej wchłania substancje, niż żołądek.
Smarując zatem codziennie skórę chemicznymi kremami, czy innymi mazidłami, narażasz swój organizm na bezpośredni kontakt z drażliwymi substancjami. O ile wywołuje one jedynie efekt alergiczny, problem nie urasta do rangi tragedii, ale coraz więcej z nich posądzanych jest o właściwości rakotwórcze, a to już nie przelewki..
Szczególnie martwią mnie antyperspiranty z aluminium i chemiczne środki do prania, bo ubrania w końcu nosimy na sobie przez 24 godziny na dobę. To ogromne wyzwanie dla skóry, która nieustannie walczy z fosforanami zawartymi w proszkach. Metal ciężki typu aluminium to z kolei substancja podejrzana o akumulację w mózgu i powiązana ze wszelkimi chorobami głowy takimi jak autyzm, Alzheimer, Parkinson, stwardnienie rozsiane, stwardnienie zanikowe boczne, demencje.
Wysypka, alergie, czy podrażnienia skóry to jedynie zewnętrzne objawy buntu organizmu wobec lawiny chemikaliów, którymi go bombardujesz. Gorzej sprawa wygląda wewnątrz ciała, gdzie taka substancja trafia prosto do krwioobiegu, często kumulując się w tkankach i zatruwając Twój organizm od wewnątrz.
Czytaj więcej:
- pobierz darmowy e-book “Szkodliwe substancje kosmetyczne” zawierający najgorźniejsze środki chemiczne dodawane so kosmetyków.
Czytaj więcej:
-
Toksyny są wśród nas. Czy warto z nimi walczyć? Cz. 1
-
Toksyny są wśród nas. Skorowidz toksyn. Cz. 2
-
Endometrioza, a kseno i pseudoestrogeny
-
Toksyny, a choroba autoagresywna
-
Jak się mają pasożyty i solwenty do endometriozy?
-
Endometrioza, a syntetyczne hormony
-
Endometrioza, a dioksyny
Źródła:
- Walter Last – Proste metody przywracania zdrowia, 2014
- Andreas Moritz – Ponadczasowe tajemnice zdrowia i odmładzania – Tom I, 2013
- Andreas Moritz – Ponadczasowe tajemnice zdrowia i odmładzania – Tom II, 2013
- Bruce Fife – Jak pokonać Alzheimera, Parkinsona, SM i inne choroby neurologiczne, 2014
- David Perlmutter, Carol Colman – Księga zdrowia mózgu, 2014
- Amy Myers – The Autoimmune Solution, 2015
- Hulda Regehr Clark – Kuracja życia, 2006